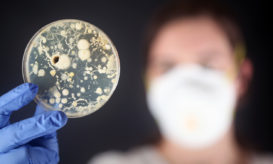
ιώσεις

Μπορεί ο ψευδάργυρος να μας βοηθήσει όταν έχουμε ίωση; Τι απαντά η επιστήμη
Τι μπορεί και τι δεν μπορεί να προσφέρει. Η συνιστώμενη δόση και οι πιθανές ανεπιθύμητες ενέργειες.

Τι μπορεί και τι δεν μπορεί να προσφέρει. Η συνιστώμενη δόση και οι πιθανές ανεπιθύμητες ενέργειες.

Οι διαφορές στα συμπτώματα που προκαλούν οι ιώσεις και η καταβολή των δυνάμεων λόγω υποχρεώσεων.

Τι έχουν δείξει οι έως τώρα μελέτες με τη βιταμίνη. Ποια μπορεί να μας βοηθήσει ουσιαστικά.

Τι έδειξε πρόσφατη ανασκόπηση της ιατρικής βιβλιογραφίας για τις επιδράσεις του στο κοινό κρυολόγημα.

Πόσο πιθανό είναι να πάθετε ίωση αν βγείτε έξω με βρεγμένο κεφάλι και πόσο σας προστατεύει η βιταμίνη C.

Ο ρόλος των ορμονών, της στάσης του σώματος και του βιολογικού ρολογιού. Τι λένε οι ειδικοί.

Ο ρόλος της «μνήμης» του ανοσοποιητικού και πρακτικές συμβουλές για να το τονώσετε.
Πώς εισβάλλουν οι ιοί στον οργανισμό μας και τι συμπτώματα μπορεί να προκαλέσουν.

Σε ποιες περιπτώσεις πρέπει να επικοινωνήσετε οπωσδήποτε με τον γιατρό σας. Γιατί να μην περιμένετε.

Οι συστάσεις από τους ειδικούς της Αμερικανικής Εταιρείας Καρδιάς (ΑΗΑ). Πότε να πάτε στον γιατρό.

Τι έδειξε νέα μελέτη που εξέτασε ασθενείς με γρίπη, κοινό κρυολόγημα (ιώσεις) και κορωνοϊό. Ποια συμπτώματα επιμένουν.

Ποια τρόφιμα και ροφήματα να προτιμάτε και ποια να αποφεύγετε όταν έχετε γρίπη ή άλλη λοίμωξη του αναπνευστικού

Τι να προσέξετε τις μέρες πριν το ρεβεγιόν και το οικογενειακό τραπέζι. Ο ρόλος που παίζουν οι συνήθειες του...

Οι λοιμώξεις που προκαλούνται από ιούς μπορεί να είναι μεταδοτικές για αρκετές ημέρες πριν και μετά την εκδήλωσή τους....

Τέσσερις συμβουλές από δύο βρετανούς καθηγητές για να καταπολεμήσετε τα συμπτώματα του αναπνευστικού και τους πόνους στο σώμα που...